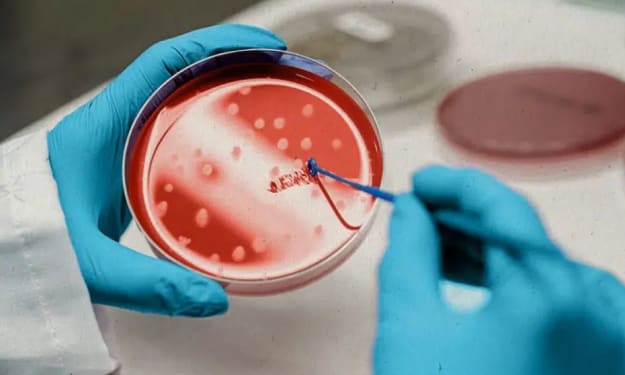

How To Deal with Information Management?
As the pace of business continues to accelerate, many organizations are struggling to keep up with the pace of change. Whether it's a result of increased digitalization or an increased focus on sustainability, the need to manage information more efficiently is growing. In fact, it's one of the top five challenges that executives across all industries continue to face. And as a business owner or executive, you are likely already aware of this growing need. That's why we've put together a list of five simple steps that you can take to improve your organization's information management. From standardizing data capture and meta-data management to streamlining information storage and retrieval, these five steps will help you create a more efficient information management system for your company. So, without any further ado, let's get started!